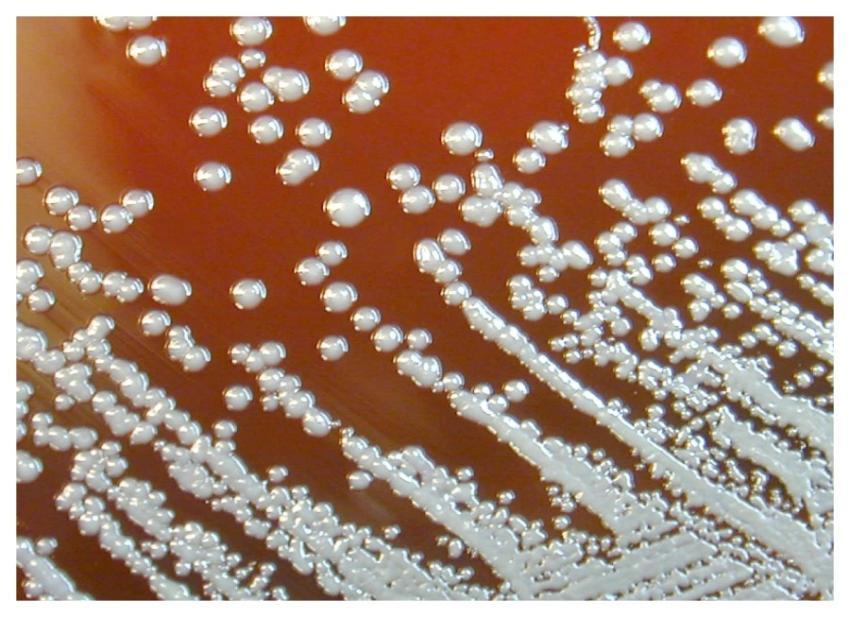
A close view of a Petri dish culture plate, which

bacteria
Tagged photos (33)
A medical illustration of Clostridioides difficile
by Dr. Ursula Hills II

A medical illustration of Clostridioides difficile
by Dr. Ursula Hills II

Photomicrograph of Giemsa stained lung tissue. Ori
by Dr. Ursula Hills II

Photomicrograph of Giemsa stained lung tissue. Ori
by Dr. Ursula Hills II

A 100X photomicrograph magnification of a malachit
by Prof. Devin Ullrich MD

Photomicrograph of a brain tissue specimen. Origin
by Kayli Funk

A 100X photomicrograph magnification of histopatho
by Kayli Funk

A close view of a Petri dish culture plate, which
by Prof. Marley Goyette I
Transmission electron microscopic (TEM) image, rev
by Kayli Funk

Local health centers experimenting with coronaviru
by Dr. Ursula Hills II

Photomicrograph of a blood smear specimen. Origina
by Mrs. Malika Stoltenberg

A 3D graphical representation of a number of norov
by Prof. Denis Frami I


